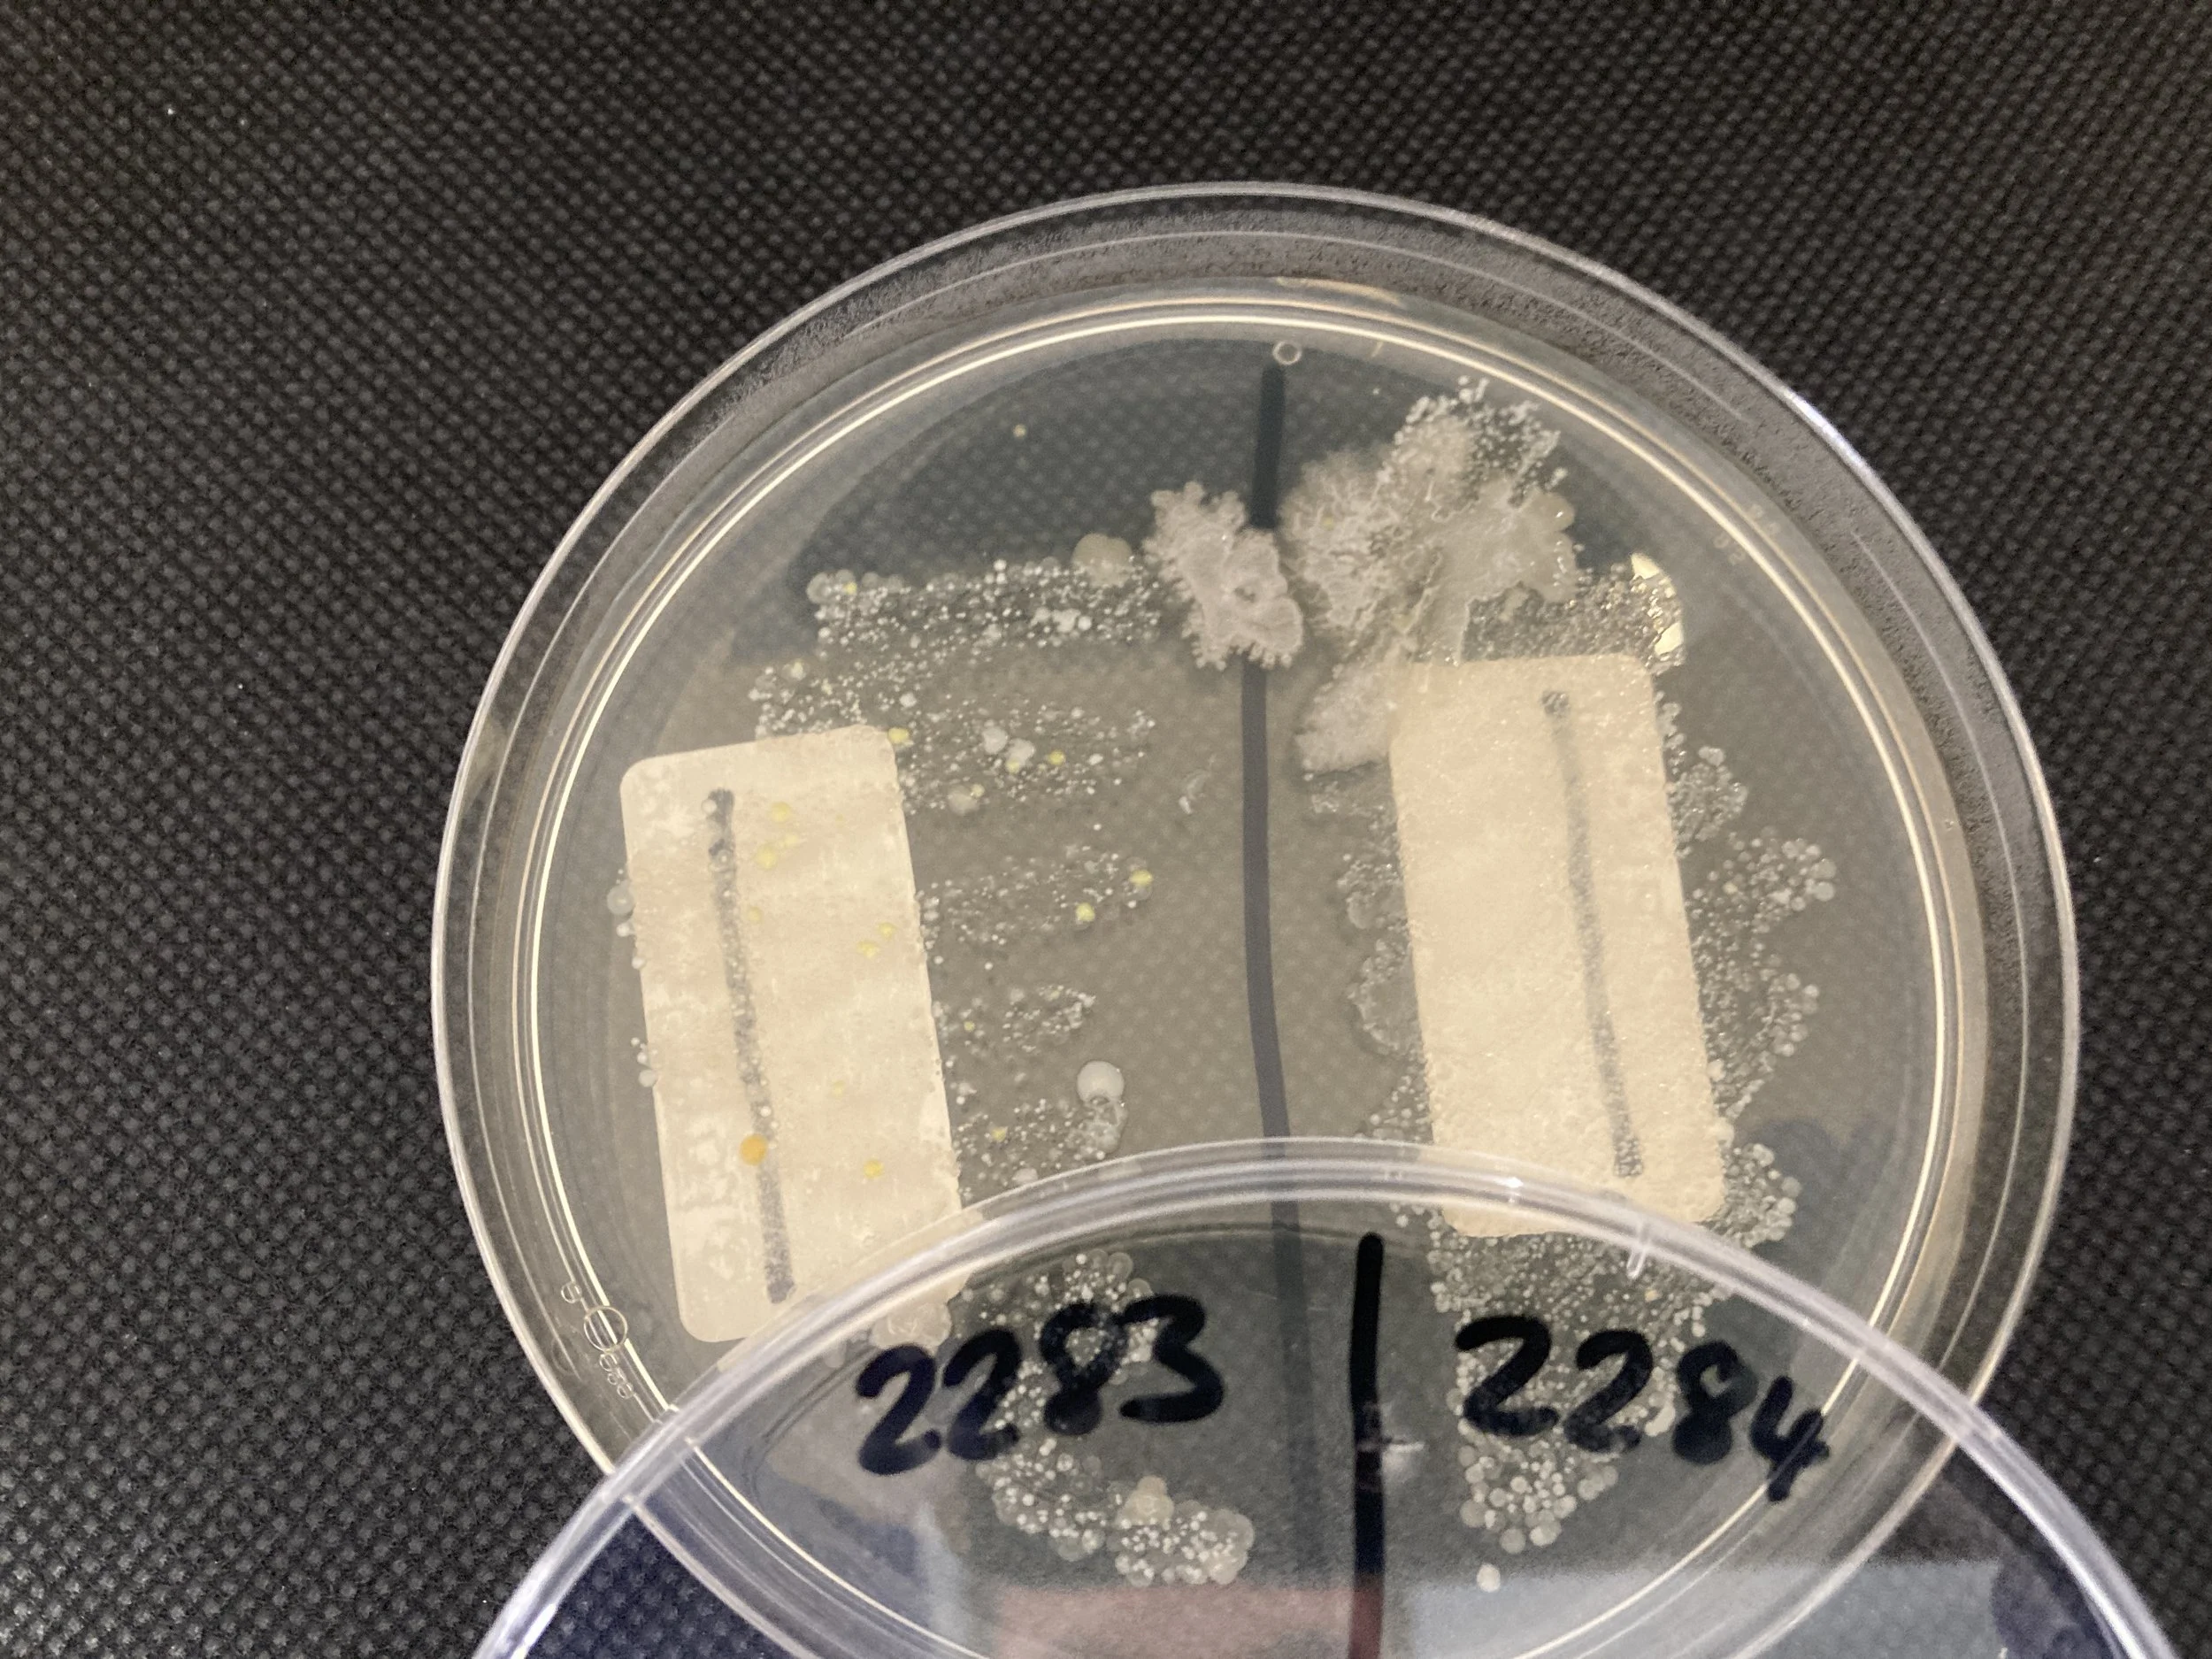
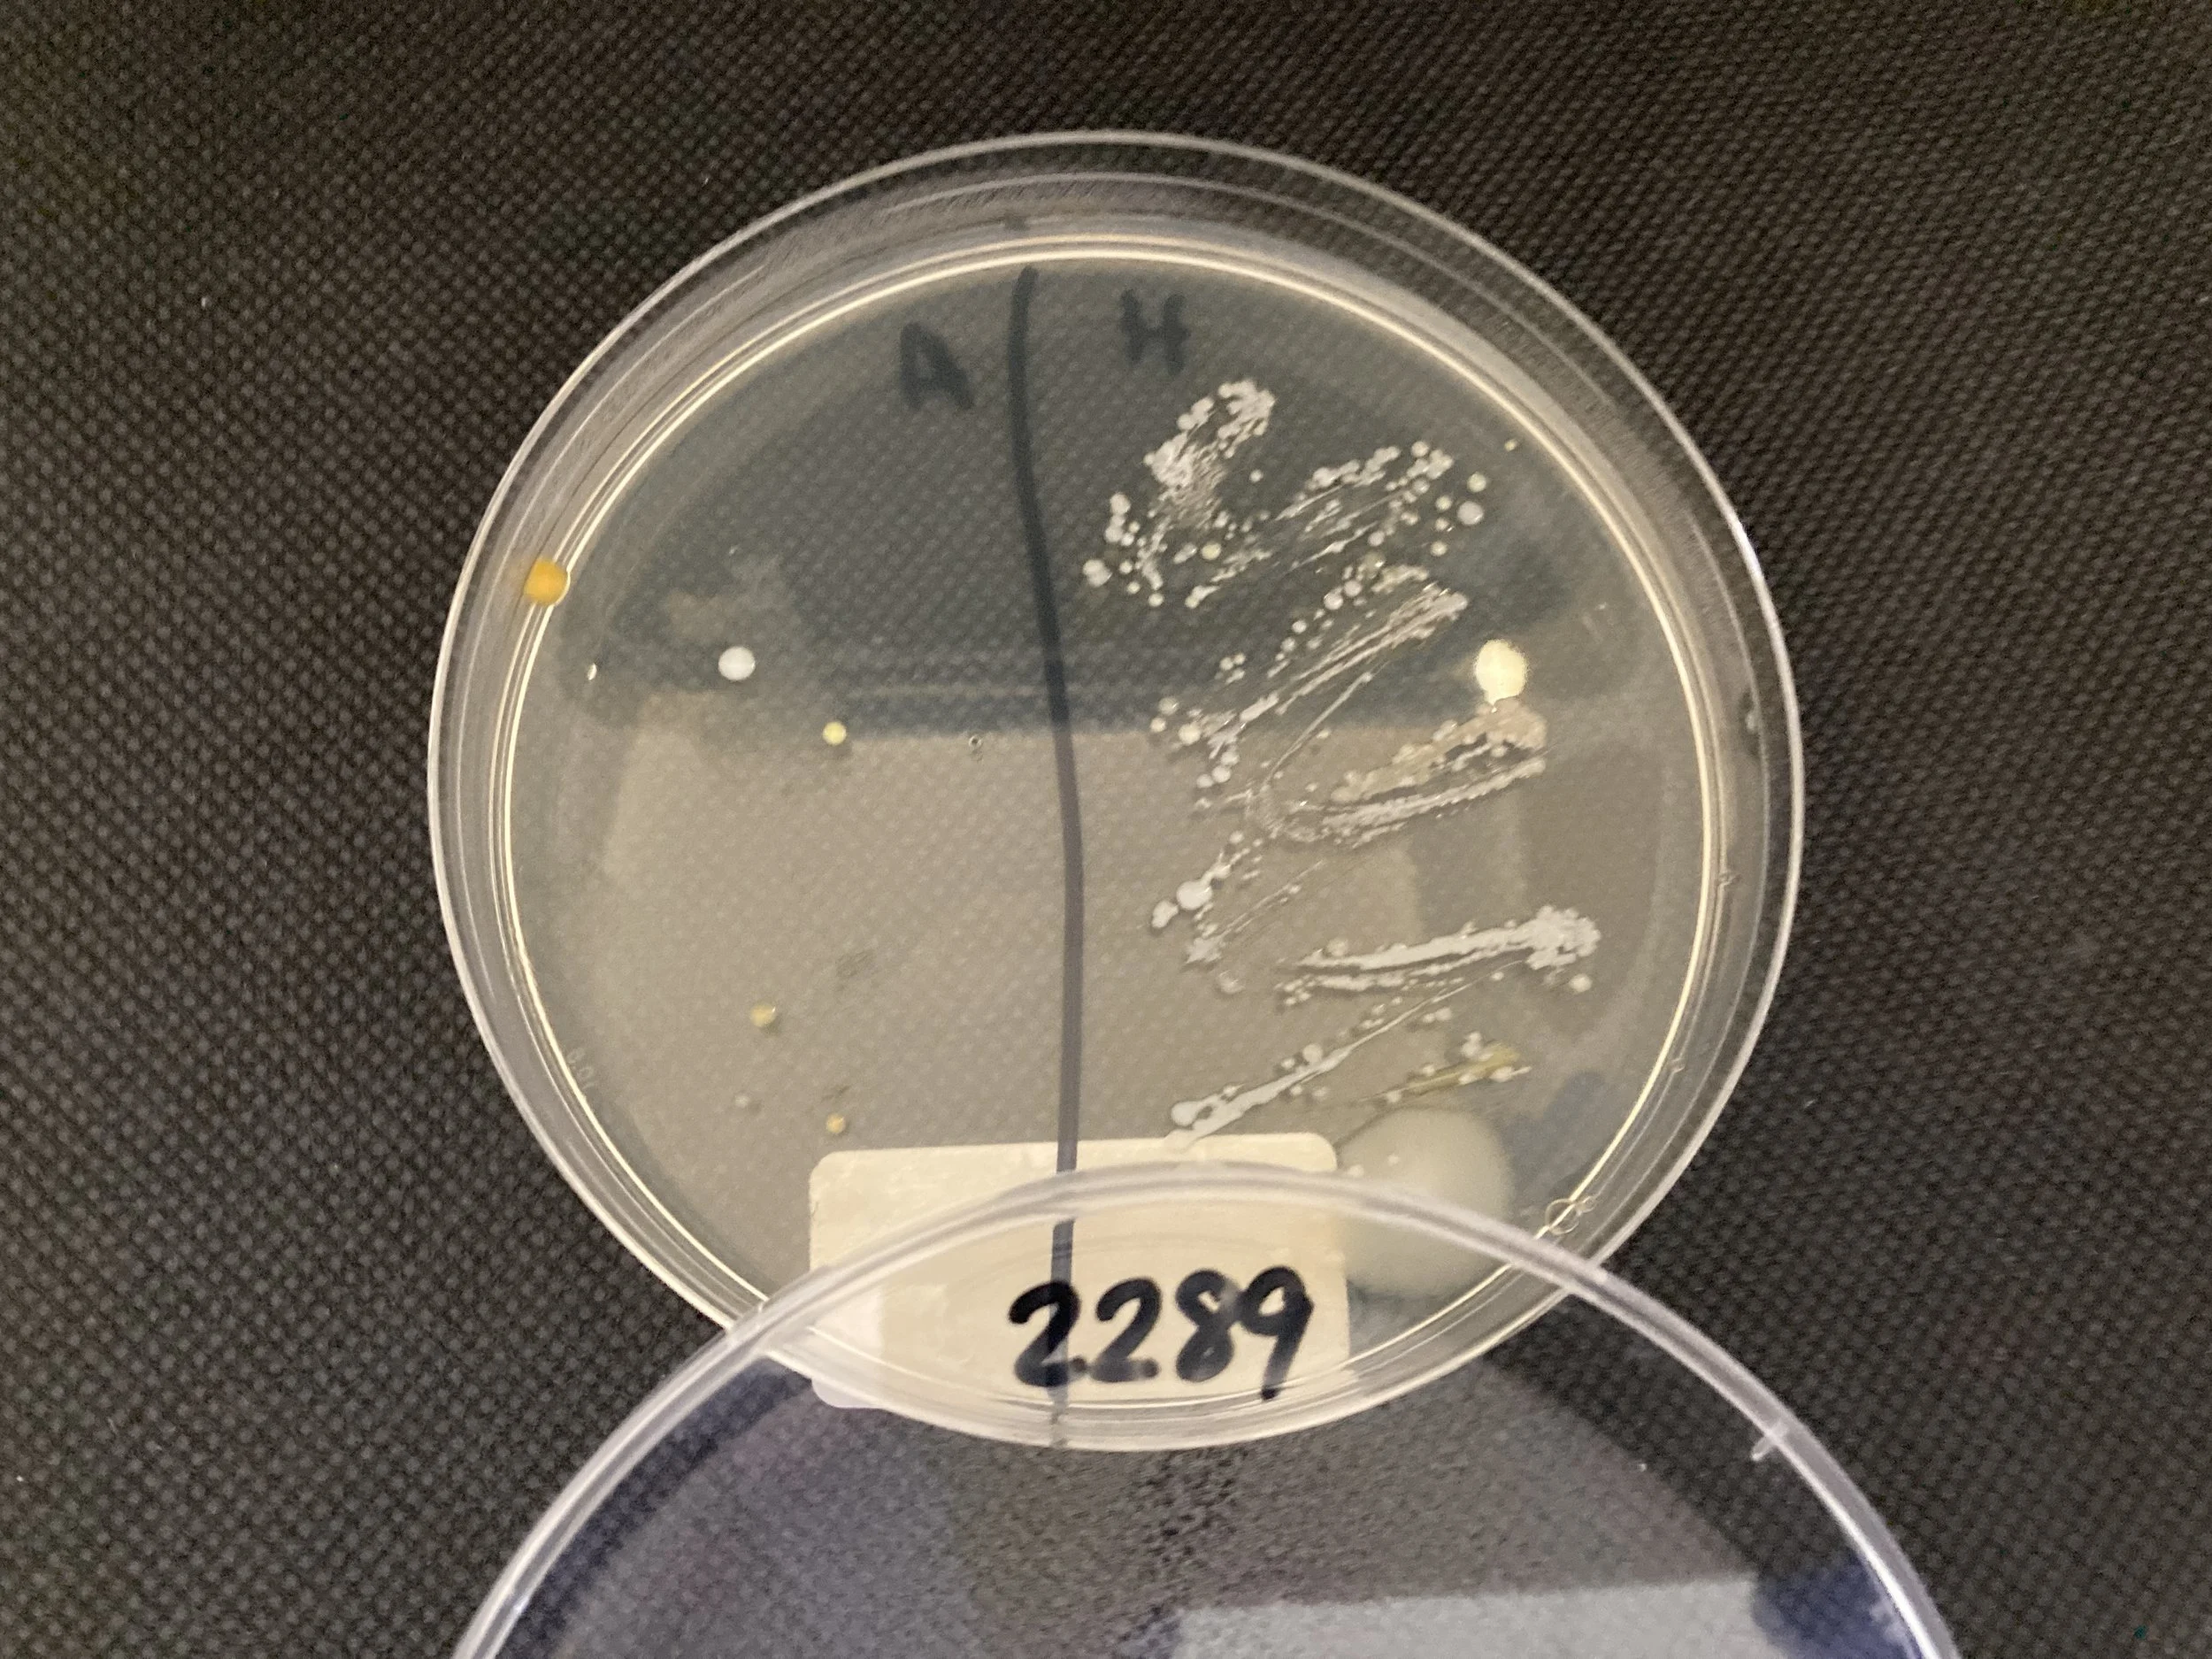
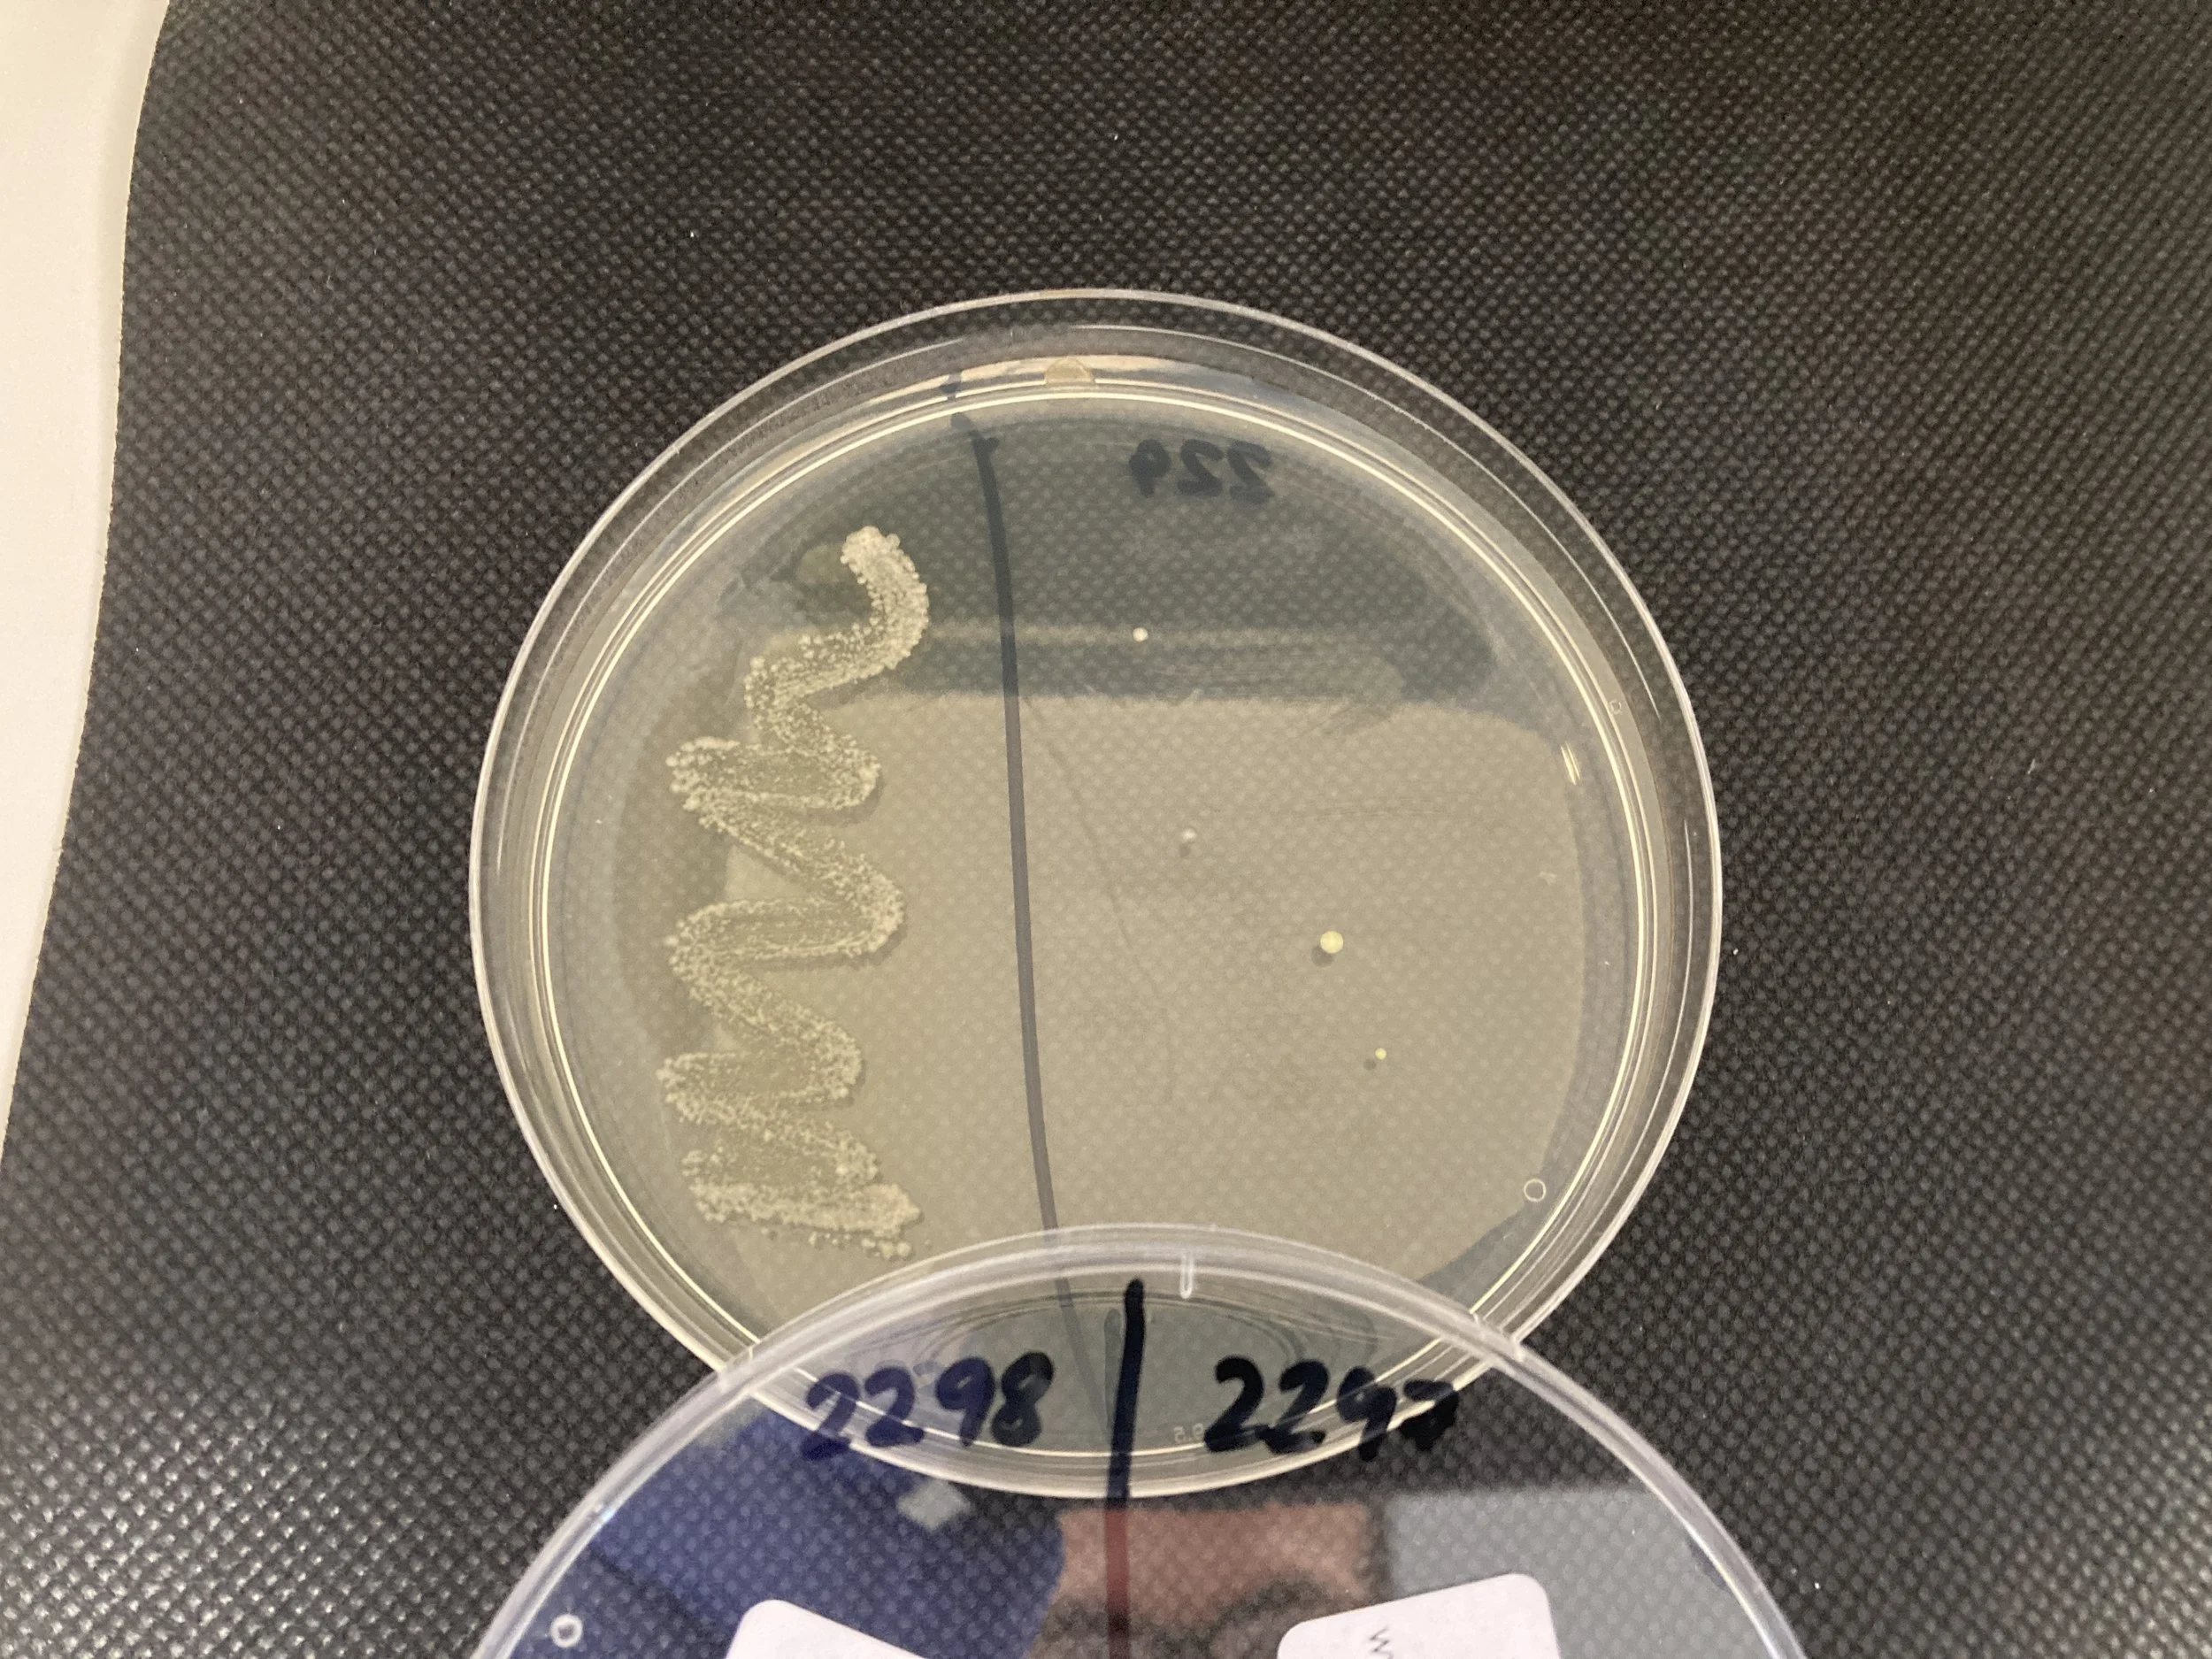
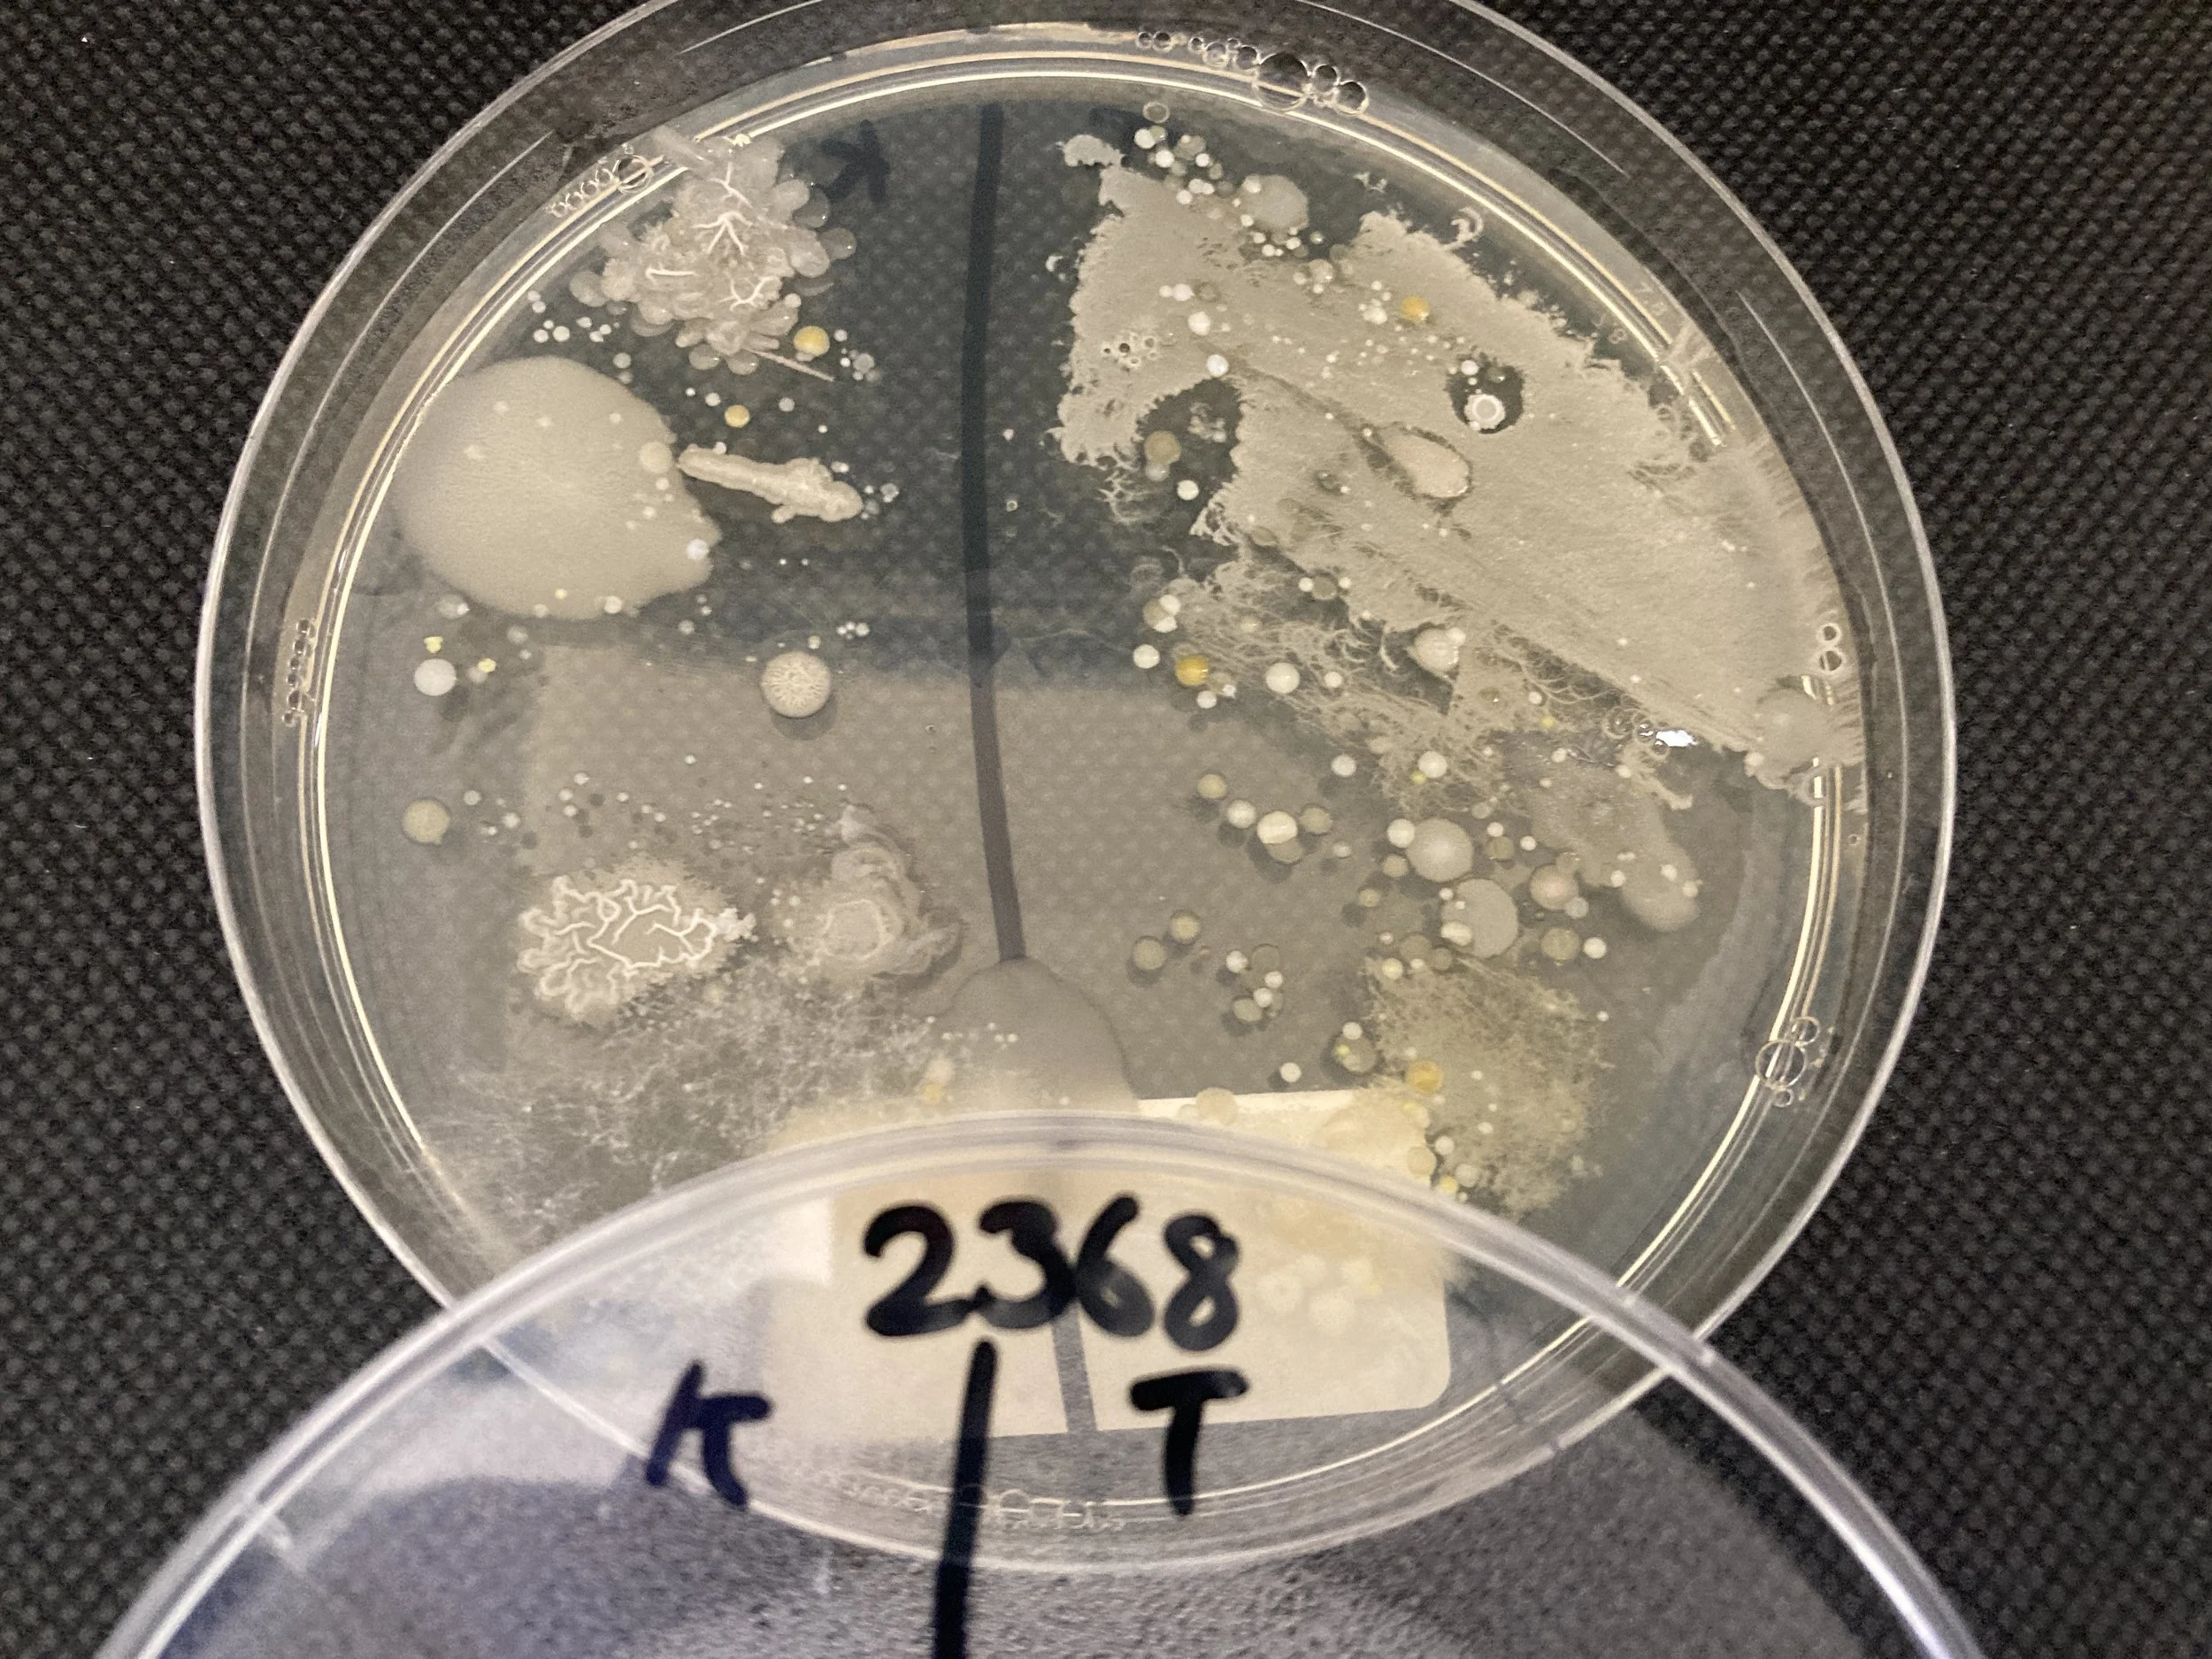
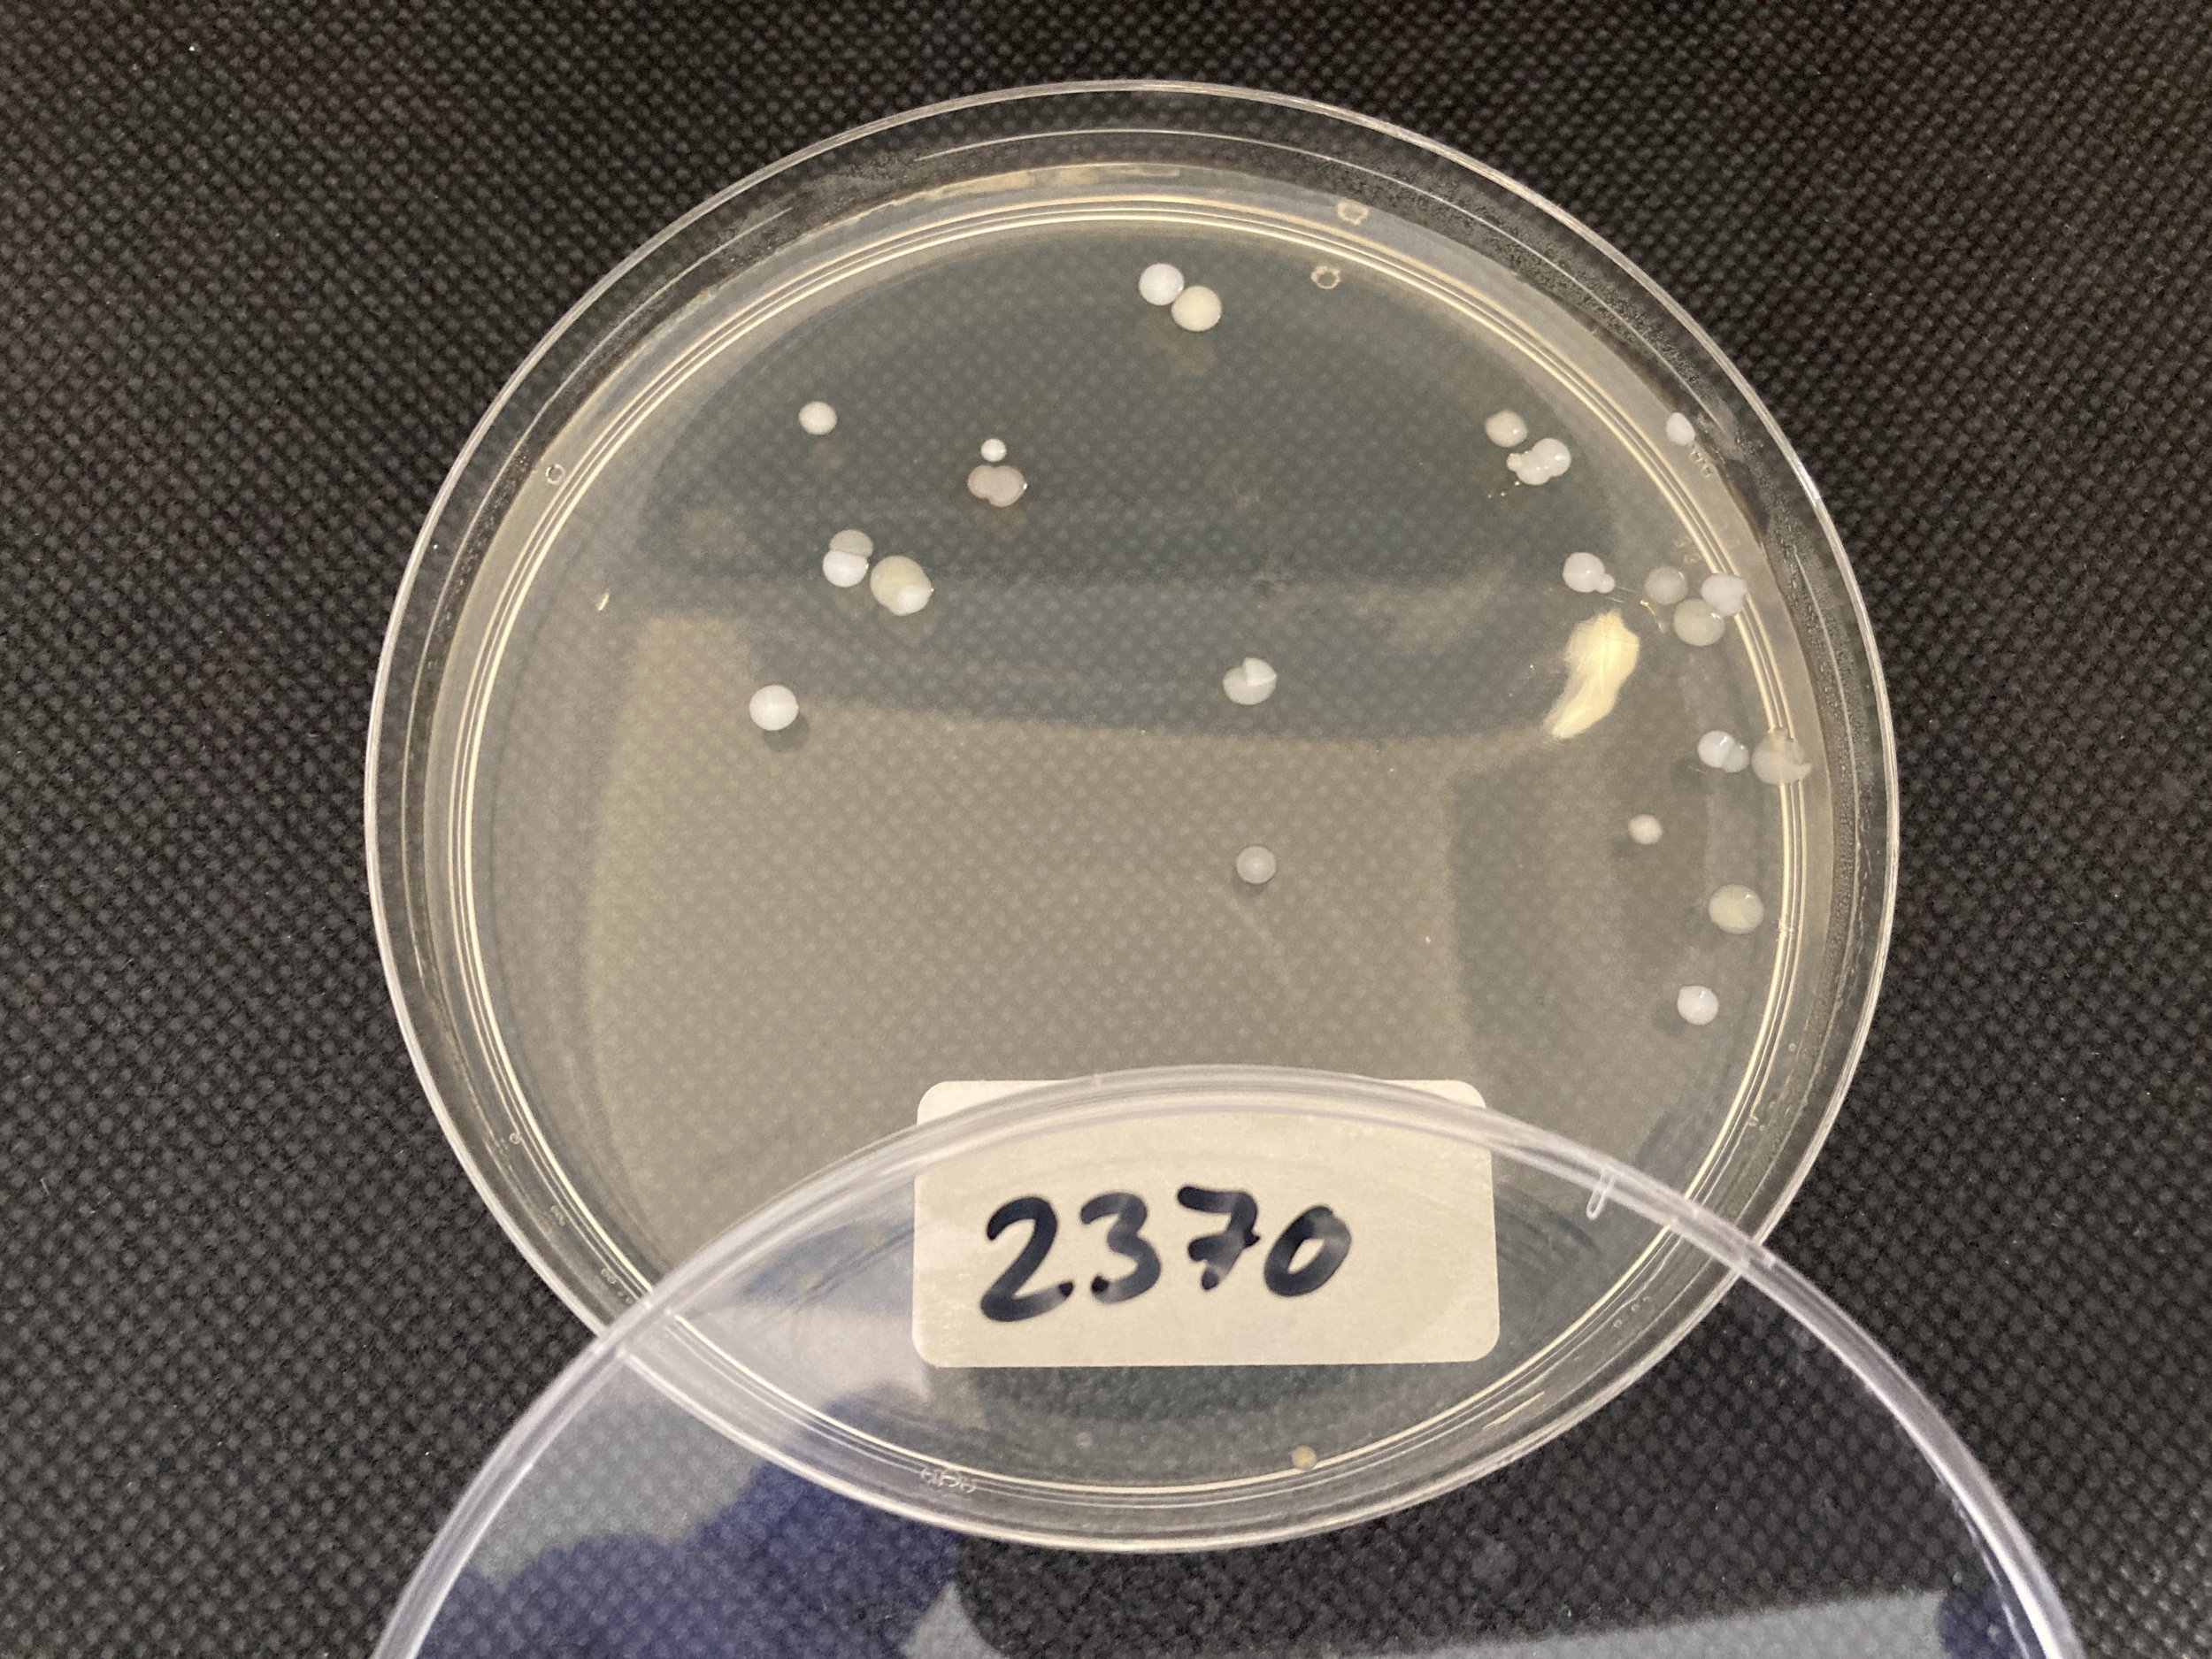

Photo album: Broadlands Fun Day 2023
Written By Matthias Eberl
Photos from the Mini Science Festival at the Broadlands Fun Day in Bridgend on 2nd September 2023
Matthias is Professor for Translational Immunology at Cardiff University where he leads a research group investigating the immune response to acute bacterial infections. He is also Academic Lead for Public Involvement and Engagement at Cardiff’s School of Medicine and a core member of the Superbugs team.